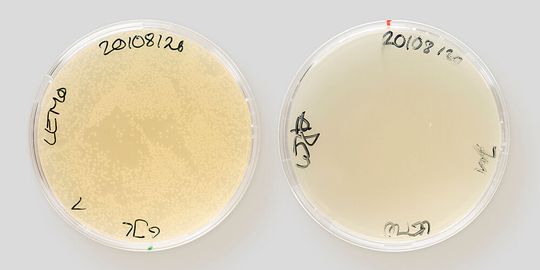
Zwei Petrischalen mit Bakterienkulturen. Darobactin hat alle Bakterien der rechten Schale vernichtet, in der Kontrolle links sind sie noch deutlich sichtbar als helle Kolonien. Zwei Petrischalen mit Bakterienkulturen. Darobactin hat alle Bakterien der rechten Schale vernichtet, in der Kontrolle links sind sie noch deutlich sichtbar als helle Kolonien.

Neues Antibiotikum wirkt anders als üblich Wie ein abgebrochener „Schlüssel“ Erreger ausschaltet
Antibiotika sind das Bollwerk der Medizin. Doch es bröckelt, weil mehr und mehr Erreger Resistenzen entwickeln. Neue Wirkstoffe sind gefragt – wie Darobactin. Dieses Molekül ist zwar zu groß, um wie andere Wirkstoffe in Erreger eindringen zu können. Es wirkt aber trotzdem. Warum dabei ein besonderer Mechanismus das Aufkommen von Resistenzen sogar erschwert, fanden Forscher der Universität Basel heraus.
Anbieter zum Thema

Basel/Schweiz – Die gefährlichsten Keime haben eines gemeinsam: Sie verfügen über eine doppelte Membran, die schwer zu durchdringen ist. Und selbst wenn antibiotische Wirkstoffe diese Hülle knacken und ins Innere eindringen, werden sie von den Bakterien meist gleich wieder hinausgepumpt. Anders bei dem kürzlich entdeckten Antibiotikum Darobactin: das umgeht die Schutzvorkehrungen der Krankheitserreger und tötet alle Problemkeime ab. Wie dem antibiotischen Molekül das gelingt, haben die Professoren Sebastian Hiller und Timm Maier mit ihrem Team vom Biozentrum der Universität Basel nun aufgeklärt.
Zu groß und doch genau richtig – das etwas andere Antibiotikum
Antibiotika entfalten ihre Wirkung üblicherweise, indem sie in Bakterien eindringen. Das neu entdeckte Darobactin ist dafür jedoch viel zu groß. Die Baseler Wissenschaftler fanden heraus, dass Darobactin durch ein Täuschungsmanöver erfolgreich gegen die Keime wirkt: Das Molekül ähnelt mit seiner Form einer besonderen dreidimensionalen Struktur, die sonst nur diejenigen Proteine besitzen, welche von Bakterien als Bausteine für ihre äußere Membran selbst produziert werden. Die besagte Struktur ist der Schlüssel, um die Proteine an bestimmten Orten von innen her in die äußere Hülle des Bakteriums einzupassen. Darobactin ist eine Kopie dieses Schlüssels. Doch es nutzt dies nicht, um in die Bakterien einzudringen, sondern blockiert lediglich das Schlüsselloch von außen. So, als würde man eine Tür abschließen und dann den Schlüssel abbrechen. Die Folge: Den Bakterien ist der Transportweg für ihre Hüllenbausteine versperrt und sie sterben.
Winziges Protein, große Wirkung
Aus-Schalter für Salmonellen-Infektion entdeckt
Verwandte Mechanismen sind in der Mikrobiologie bereits bekannt und werden durch andere Medikamente verwendet. Die dabei anvisierten Bindestrukturen, oder eben Schlüssellöcher, sind in der Regel recht groß – zumindest für mikrobiologische Verhältnisse. Im Gegensatz dazu ist das von Darobactin genutzte Ziel sehr klein und mit üblichen Methoden gar nicht erkennbar. Dabei ist das Darobactin-Molekül selbst größer ist als die meisten Wirkstoffe und würde gar nicht erst durch die Eintrittspforten der Bakterien passen.
Resistenzbildung gegen Darobactin ist unwahrscheinlich
Die Forscher der Uni Basel fanden heraus, dass Darobactin eine wahre Achillesferse der Erreger angreift, und zwar an dem Protein BamA, welches beim Aufbau der doppelten Schutzmembran eine zentrale Rolle einnimmt. Darobactin bindet direkt an die wichtigsten, so genannten Rückgrat-Atome von BamA. Damit haben die Bakterien kaum eine Chance, sich gegen den Wirkstoff zu verteidigen. Denn die Rückgratatome sind essenziell für den Zusammenhalt und die Form des Proteins und können nicht einfach verändert werden – damit ist es unwahrscheinlich, dass der Erreger mit Mutationen in absehbarer Zeit eine Resistenz gegen den Wirkstoff entwickelt.
Um das zu überprüfen, nutzten die Wissenschaftler Labortests, mit denen sich künstlich Resistenzen in Bakterien erzeugen lassen. Doch beim Darobactin blieb die Wirksamkeit gegen alle überprüften Erreger erhalten. Es gelang den Erregern nicht, das durch den Wirkstoff blockierte Schloss auszuwechseln.
„Die Aufschlüsselung des Wirkmechanismus von Darobactin ist ein großer Erfolg, denn das ermöglicht es, Darobactin gezielt zu verbessern und zu einem wirksamen Medikament zu entwickeln“, sagt Dirk Bumann von der Uni Basel. Die langgehegte Hoffnung auf eine neue Generation Antibiotika, die gegen viele der heutigen Problemkeime eingesetzt werden kann, erhalte damit starken Auftrieb.
Originalpublikation: Hundeep Kaur et al.: The antibiotic darobactin mimics a β-strand to inhibit outer membrane insertase, Nature (2021), DOI: 10.1038/s41586-021-03455-w
(ID:47357062)

